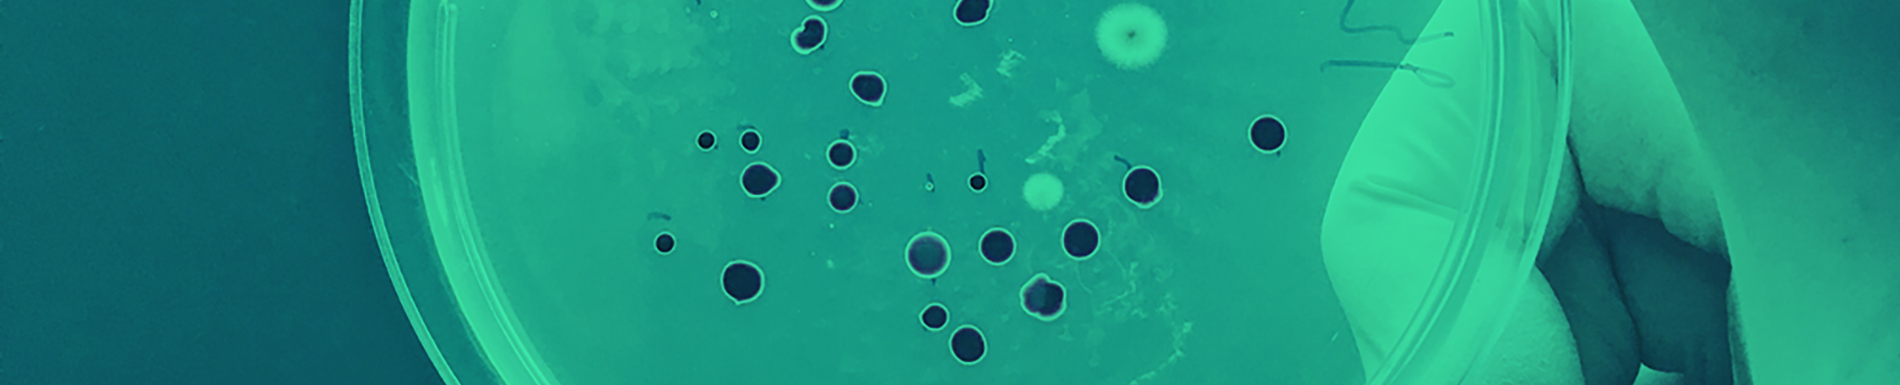
realisation/probiotiques_rm4QIby.jpg

Les probiotiques sont des bactéries utiles pour les humains et les animaux. Grâce à un développement biotechnologique spectaculaire, ils sont maintenant utilisables dans les produits de nettoyage.
R&O Lab élabore des formules concentrées en probiotiques qui donnent des résultats incroyables dans l’entretien et le nettoyage professionnel. Contrairement aux produits chimiques classiques, les probiotiques de surface sont sans danger pour l’homme et son environnement.
• Totalement inoffensifs pour les humains et les animaux
• Ils fournissent un nettoyage microscopique efficace
• Ils éliminent les déchets organiques
• Ils assurent un équilibre biologique sain et sécurisé
• Ils éliminent activement les molécules organiques responsables des mauvaises odeurs
• Action de plusieurs jours